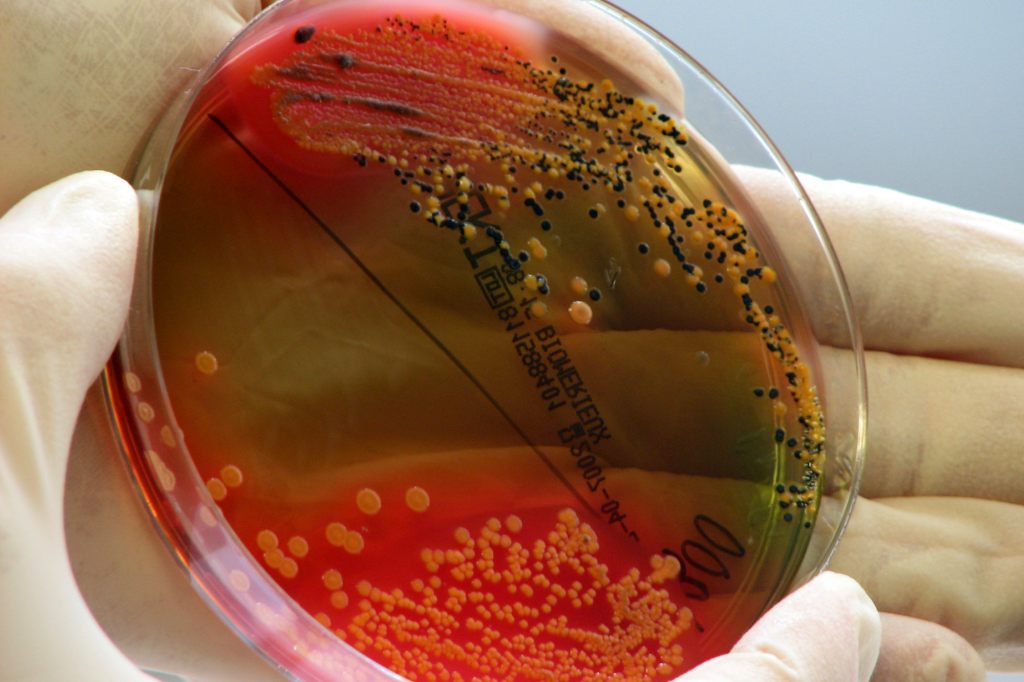
Tod von Deutschen in Istanbul stellt Ermittler vor Rätsel

Tod von Deutschen in Istanbul stellt Ermittler vor Rätsel
Baseljetzt
Mehrere Tage nach dem Tod einer Hamburger Mutter und ihrer zwei Kinder bei einem Türkeiurlaub in Istanbul gibt der Fall den Ermittlern Rätsel auf. Bislang gehen die Behörden von Lebensmittelvergiftung als Ursache aus, ermittelt wird jedoch in mehrere Richtungen.
Zuletzt war auch das Hotel der Familie in den Fokus geraten, nachdem zwei weitere Touristen mit Vergiftungserscheinungen ins Krankenhaus eingeliefert worden waren.
Die Behörden evakuierten das Hotel im Stadtteil Fatih nach Angaben der staatlichen Nachrichtenagentur Anadolu am Samstagabend und versiegelten das Gebäude. Die Gäste wurden verlegt. In Istanbul wurde offiziellen Angaben zufolge kein ungewöhnlicher Anstieg von Lebensmittelvergiftungsfällen festgestellt.
Acht Verdächtige festgenommen
Medienberichten zufolge wurden inzwischen acht Verdächtige festgenommen: bereits am Freitag vier Streetfood-Verkäufer, am Samstag drei weitere Verdächtige, darunter ein Verantwortlicher des Hotels, und zuletzt ein Bäcker aus der Gegend des Hotels. Ob die Festnahmen miteinander in Zusammenhang stehen, war unklar. Die Behörden äusserten sich zunächst nicht.
Die Spurensicherung der Polizei nahm Anadolu zufolge auch Proben des Trinkwassers und nahm sämtliche Gegenstände mit, um sie im Labor zu untersuchen. Ein Zimmer im Erdgeschoss sei zudem mit Chemikalien desinfiziert worden – mutmasslich handele es sich dabei um Pestizide zur Schädlingsbekämpfung.
Vater aus Hamburg weiter auf Intensivstation
Vater, Mutter, der sechs Jahre alte Sohn und die drei Jahre alte Tochter waren vor einer Woche nach Istanbul gereist. Am Mittwoch war die Familie Anadolu zufolge wegen Übelkeit und Erbrechens in ein Krankenhaus mit Verdacht auf Lebensmittelvergiftung eingeliefert und zwischenzeitlich entlassen worden.
Nachdem sich der Zustand verschlechtert hatte, wurde die gesamte Familie in der Nacht erneut in ein Krankenhaus gebracht. Kurz darauf starben beide Kinder, danach am Freitag die Mutter. Der Vater liegt nach wie vor auf der Intensivstation – über seinen Zustand ist nichts Neues bekannt.
Genaueren Aufschluss über die Todesursache sollen Laborergebnisse geben, die noch ausstehen. Ein erster Autopsiebericht lieferte Anadolu zufolge kaum nennenswerte Hinweise.
Weitere Touristen nicht in Lebensgefahr
Die drei Hamburger wurden am Samstag im westtürkischen Afyonkarahisar beigesetzt. Bei den neuen Krankheitsfällen handele es sich um Touristen aus Italien und Marokko.
Der Chef der Istanbuler Gesundheitsdirektion, Abdullah Emre Güner, schrieb auf X, der Zustand der beiden Touristen sei gut, sie würden weiter beobachtet. Ein weiterer Urlauber, der mit den beiden im Zimmer übernachtete, sei wegen eines verlangsamten Herzschlages untersucht worden. Sein Zustand sei gut.
Bei den vier Festgenommenen von Freitag handelt es sich dem Staatssender TRT zufolge um Verkäufer von Süssigkeiten, gefüllten Muscheln und einem Gericht aus Kalbsdärmen (Kokorec). Ihnen werde fahrlässige Tötung vorgeworfen, berichtete Anadolu. Demnach sind alle Verdächtigen wegen anderer Delikte vorbestraft. Die Behörden liessen zudem einen Laden schliessen, in dem die Familie gegessen haben soll. (sda/jab)
Mehr dazu
Feedback für die Redaktion
Hat dir dieser Artikel gefallen?
Kommentare lesen?
Um Kommentare lesen zu können, melde dich bitte an.



Kommentare
Dein Kommentar
Mit dem Absenden dieses Formulars erkläre ich mich mit der zweckgebundenen Speicherung der angegebenen Daten einverstanden. Datenschutzerklärung und Widerrufshinweise